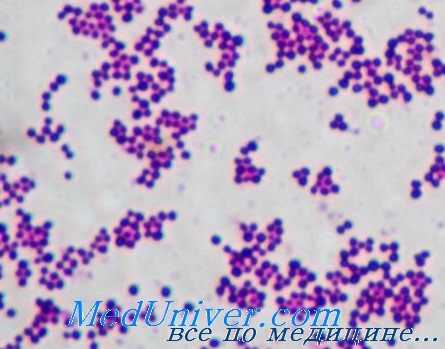
золотистый стафилококк
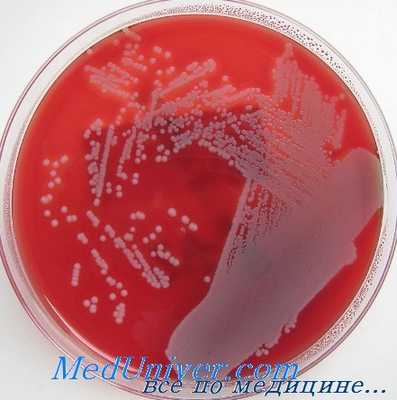
золотистый стафилококк
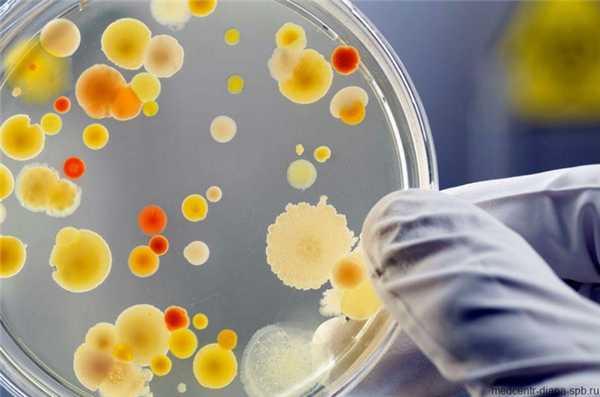
Стафилококк у взрослых и детей: гнойничковые заболевания кожи нужно лечить у врача!

Инфекции эпидермального стафилококка (Staphylococcus epidermidis): диагностика, лечение, профилактика
Добавил пользователь Валентин П. Обновлено: 27.01.2026
Инфекции золотистого стафилококка (Staphylococcus aureus): диагностика, лечение, профилактика
Представители этого рода — неспорообразующие неподвижные грамположительные кокки, формирующие при росте колонии в виде виноградной грозди (кластера) и входящие в состав нормальной микрофлоры кожного покрова животных и человека.
Стафилококки — представители семейства Micrococcaceae. Существует свыше 26 видов стафилококков, но лишь некоторые из них представляют угрозу для здоровья человека. Самым опасным считают золотистый стафилококк (Staphylococcus aureus), отличающийся от остальных наличием фермента коагулазы.
Staphylococcus aureus
Этот вид долгое время считали единственным патогенным микроорганизмом в своём роде. Носительство S. aureus у человека обычно протекает бессимптомно; его обнаруживают у 40% здорового населения.
Обычно он локализуется на слизистой оболочке носа, коже подмышечной области и промежности.
Патогенез инфекции золотистого стафилококка (Staphylococcus aureus)
Коагулаза, продуцируемая Staphylococcus aureus, катализирует реакцию превращения фибриногена в фибрин и помогает микроорганизму образовывать защитный барьер. Кроме того, наличие рецепторов к поверхностным структурам клеток хозяина и матричным белкам (например, фибронектину, коллагену) обусловливает возможность адгезии возбудителя.
Он вырабатывает экстрацеллюлярные лизирующие ферменты (липазу), разрушающие ткани и способствующие инвазии. Некоторые штаммы продуцируют сильнейший экзотоксин, вызывающий синдром токсического шока. Выделяемые бактерией энтеротоксины могут быть причиной диареи.
Клиническая значимость золотистого стафилококка (Staphylococcus aureus)
Staphylococcus aureus вызывает различные заболевания. Кожные инфекции возникают в условиях повышенной температуры и влажности, а также в связи с нарушением целостности кожного покрова при некоторых заболеваниях (экзема и др.), хирургических операциях, инъекциях или внутривенной катетеризации. Даже на здоровой коже может развиться поверхностная пиодермия (импетиго), которая затем передаётся от человека к человеку.
Пневмонию, вызванную S. aureus, наблюдают достаточно редко (в большинстве случаев в качестве осложнения гриппа). Инфекция быстро профессирует (часто наблюдают образование полостей или каверн); характерен высокий уровень смертности. Быстрое течение свойственно и стафилококковому эндокардиту, возникающему при неправильном подборе антибиотиков или вследствие микробной колонизации внутривенных устройств. Заболевание часто приводит к смерти пациента. Кроме того, S. aureus — наиболее распространённая причина остеомиелита и септического артрита.
Лабораторная диагностика золотистого стафилококка (Staphylococcus aureus)
• Бактериологическое исследование: S. aureus — грамположительные кокки, располагающиеся в микропрепарате в виде виноградной грозди. Быстро растут на большинстве питательных сред. Выдерживают высокие концентрации солей, поэтому диагностическая среда может быть приготовлена с учётом этой особенности микроорганизма.
• Изучение биохимических свойств: большинство штаммов S. aureus разлагают маннитол, поэтому добавление его и характерного красителя помогает идентифицировать субкультуру бактерий. Продуцируют коагулазу, ДНКазу, каталазу.
• Типирование S. aureus с помощью набора типовых стафилококковых бактериофагов или методом рестрицирования ДНК.
Чувствительность золотистого стафилококка (Staphylococcus aureus) к антибиотикам
Изменение чувствительности S. aureus к антибиотикам можно считать настоящим пособием по антимикробной химиотерапии. Сначала против золотистого стафилококка был в полной мере эффективен бензилпенициллин, но затем возникли штаммы, способные вырабатывать бета-лактамазы. Со временем они стали преобладать над всеми остальными. С внедрением в клиническую практику метициллина и родственных ему лекарственных средств (флуклоксациллина) именно они стали препаратами выбора и в настоящее время остаются таковыми при наличии чувствительных штаммов.
Позже возникли штаммы золотистого стафилококка, устойчивые к действию метициллина. Их резистентность обусловлена геном тесА+, кодирующим белки со сниженным сродством к пенициллинам. Некоторые из устойчивых штаммов способны вызвать эпидемические вспышки заболевания, для борьбы с которыми применяют ванкомицин и тейкопланин.
В настоящее время обнаруживают всё больше микроорганизмов со средней устойчивостью (или гетерорезистентностью) к гликопептидам. Описаны случаи полной гликопептидной резистентности у некоторых штаммов, обусловленной наличием генов vanA+ и vanB+ заимствованных у энтерококков.
Другими эффективными препаратами считают линезолид, аминогликозиды, эритромицин, клиндамицин, производные фузидовая кислота, хлорамфеникол и тетрациклин.
В отношении метициллинчувствительных штаммов активны цефалоспорины первого и второго поколения. Производные фузидовой кислоты применяют при комбинированной терапии инфекционных заболеваний костей и суставов. Лечение должно сопровождаться обязательным проведением теста на чувствительность к антимикробным препаратам.
Профилактика заболеваний вызванного золотистым стафилококком (Staphylococcus aureus)
Передача инфекций, вызываемых Staphylococcus aureus, происходит посредством аэрозольного и контактного механизма. Носителей или лиц, заражённых штаммами, устойчивыми к метициллину и гликопептидам, необходимо изолировать в отдельные боксы и соблюдать меры предосторожности во избежание раневого или энтерального проникновения бактерий.
Следует помнить, что медперсонал может стать носителем инфекции и способствовать её распространению в лечебном учреждении. Именно поэтому всем работникам больницы рекомендовано применение местных растворов мупироцина и хлоргексидина.
Редактор: Искандер Милевски. Дата обновления публикации: 18.3.2021
Стафилококк у взрослых и детей: гнойничковые заболевания кожи нужно лечить у врача!
Чумой нашего времени именуют стафилокковые и другие гнойно-септические заболевания. Несмотря на то что в эту сборную группу входят различные болезни, вызываемые разнородными возбудителями, все они объединяются сходными клиническими признаками и эпидемиологическими особенностями, одной из которых является их распространение в родильных домах и детских больницах.
Какие заболевания вызывают стафилококки
Основными возбудителями гнойно-септических заболеваний являются стафилококки (от греческого «стафили» — гроздья, «коккос» — ядра, шарики, что соответствует виду этих микробов под микроскопом) и стрептококки (от греческого «стрептос» — цепь).
Этим микроорганизмам мы обязаны такими заболеваниями, как фурункулы, карбункулы, пиодермии, абсцессы, флегмоны, панариции и другие нагноения кожных покровов. При поражении слизистых развиваются конъюнктивиты, стоматиты, отиты, энтериты.
Тяжелыми формами болезни являются пневмонии, остеомиелиты (поражения костной ткани) и особенно опасны септические — генерализованные воспалительные процессы во внутренних органах, когда стафилококки и другие микроорганизмы циркулируют в крови (заражение крови).
После гнойных инфекций возникают различные осложнения, в том числе такие, которые могут приводить к хроническому течению болезни, инвалидности (миокардиты, пороки сердца, тромбофлебиты, перитониты — воспаления брюшины).
Потери, связанные с утратой трудоспособности только от стафилококовых заболеваний, превышают показатели, обусловленные всеми инфекционными болезнями, за исключением гриппа. Число новорожденных и взрослых, гибнущих от стафилококковых инфекций, более чем в два раза превышает число погибших от других заразных болезней.
Устойчивость стафилококков к антибиотикам
Чем больше мы атакуем, например, антибиотиками возбудителей гнойносептических инфекций, тем чаще появляются антибиотикоустойчивые микроорганизмы.
Под влиянием антибиотиков нарушается тормозящее действие на стафилококки других микробов — обычных обитателей нашего организма. Более того, иногда антибиотики просто стимулируют развитие стафилококков и стрептококков. Поэтому без врачебного назначения самостоятельное применение антибиотиков (да и других противобактериальных средств) при возникновении гнойных поражений кожи должно быть исключено.
Любое лечение стафилококковых кожных патологий должен назначать дерматолог! Заболевания других органов лечат соответствующие специалисты — гинекологи, урологи, терапевты.
Чем опасна стафилококковая инфекция
Особенно опасен стафилококк в ассоциации с вирусами и грибами, а также при сопутствующих детских капельных инфекциях, снижающих общую реактивность организма. Недаром при многих заболеваниях наблюдаются местные или общие осложнения, вызванные стафилококками.
Так, в период гриппозных эпидемий нередки стафилококковые пневмонии, которые чаще всего и оказываются причиной длительной болезни ребенка и являются наиболее частой предпосылкой к смертельному исходу.
Стафилококковый и стрептококковый токсины обладают выраженными сенсибилизирующими свойствами, вызывая аллергии и токсические поражения сердечной мышцы, почек и других важных органов. В отличие от ряда возбудителей детских инфекций, место действия которых ограничено определенными участками тканей организма, стафилококк и стрептококк «всеядны».
Они могут быть причиной воспаления желчного пузыря (холецистит), токсической диспепсии и гастроэнтеритов, воспалений суставов (артриты), мочеполовой сферы (уретриты и эндометриты). У новорожденных стафилококковые и другие гнойные воспалительные явления начинаются с пупочной ранки или других, незаметных на первый взгляд повреждений кожи (царапины, ссадины).
Нужно подчеркнуть, что до 90% случаев возникновения сепсиса у детей раннего возраста связано со стафилококком.
Стафилококк у беременных — угроза жизни новорожденных
Источником стафилококковой инфекции в родильных домах, детских больницах и в домашних условиях могут быть гнойные поражения кожи и слизистых у взрослых — матери, окружающих, обслуживающего персонала. Поэтому отделять заразные болезни кожи от прочих инфекционных заболеваний человека нельзя.
В нормальных условиях кожа обладает защитными свойствами в борьбе с микробами, в частности, в ее выделениях содержатся антибактериальные вещества. Однако нарушения питания, общие заболевания, микротравмы кожи могут способствовать развитию патогенной микрофлоры на коже ребенка.
Активная иммунизация беременных женщин стафилококковым анатоксином, как показала практика, не оказывает вредного влияния ни на течение беременности, ни на развитие плода, снижая в то же самое время заболеваемость гнойными инфекциями матерей и новорожденных в 3—5 раз.
При этом у матери вырабатывается активный, а у ребенка — пассивный иммунитет к возбудителям таких инфекций, как отит, пневмония, кожные нагноения, ангины (тонзиллиты), ларинготрахеиты, гаймориты и другие воспалительные заболевания носоглотки.
Стафилококковые болезни у молодых людей и детей
Гнойничковые заболевания кожи называют пиодермитами, которые в зависимости от причины возникновения подразделяются на стрепто и стафилодермии. Часто наблюдается их смешанная форма — стрептостафилодермия.
Стрептодермия чаще поражает детей и юношей и локализуется обычно вокруг естественных отверстий — нос, рот, ушные раковины, то есть на участках, подвергающихся раздражению отделяемым этих полостей (слюна, слизь). Эти поражения очень контагиозны и быстро перебрасываются на здоровые участки кожных покровов. Стрептодермия передается через игрушки, пеленки, одежду, белье.
Довольно частым стрептококковым поражением кожи новорожденных является импетиго (от латинского «импетус»— внезапный, нападающий). При этом заболевании образуются плоские с дряблым складчатым покрытием полости, наполненные серозно-гнойным содержимым, — фликтены.
Сливаясь, они образуют сплошные очаги с извилистыми воспалительными очертаниями. Преимущественно поражаются открытые части тела, особенно кожа лица. Нередко припухают близлежащие лимфатические узлы, а при распространении инфекции наблюдаются явления общей интоксикации.
Другой формой гнойных поражений является пемфигуспузырчатка новорожденных. Этот вид пиодермии отличается образованием крупных пузырей, достигающих голубиного яйца и наполненных гнойным содержимым. При их разрыве образуется обнаженная ярко-красная поверхность (эрозия), легко подвергающаяся дополнительному инфицированию, в результате чего резко нарушается состояние ребенка.
Стрептококковый пемфигус крайне контагиозен, заразен и при отсутствии должных мер профилактики может вызвать массовые вспышки пиодермий в родильных домах и детских больницах.
При переезде ребенка из роддома домой нередко возникает везикулопустулезная форма пиодермии в местах, чаще всего раздражаемых потом (на затылке, шее, лбу, в паху). Появляются мелкие пузырьки с прозрачным содержимым (везикулы) величиной с булавочную головку. Затем содержимое пузырьков становится гнойным (пустула) и окружается венчиком гиперемии.
Через два-три дня пустулы лопаются или подвергаются обратному развитию и на их месте образуются поверхностные корочки. Несмотря на относительную легкость течения этой инфекции, ее осложнения бывают весьма коварны. Они выражаются в распространенных и тяжелых флегмонах, протекающих со значительной отечностью и последующим некрозом (расплавлением) подкожной клетчатки.
У грудных детей с пониженным питанием, у неправильно искусственно вскармливаемых детей, а также у более старших детей со слабыми защитными реакциями (вследствие туберкулезной или другого рода интоксикации) стрептококковая инфекция не ограничивается поверхностным поражением кожи, а захватывает глубже лежащие ткани, образуя глубокие язвы — эктимы.
Они возникают на наиболее часто травмируемых частях тела (поясница, голени) и отличаются вялым, длительным течением. После их излечения остаются рубцы.
Говоря о стрептококковых пиодермиях у детей, нельзя обойти молчанием рожистое воспаление, особенно часто поражающее лицо (отсюда и название — «рожа»). Кожа лица становится красной, отечной. Заболевание сопровождается повышением температуры, иногда тяжелым общим состоянием, требующим принятия экстренных лечебных мер.
Известна также так называемая «заеда» — стрептококковая фликтена (разновидность импетиго) в углах рта, которая вскрывается и образует длительно незаживающую ранку, постоянно возобновляющуюся в связи с мимическими движениями мышц лица и приемом пищи. При недостаточном санитарном контроле заеда может вызывать настоящие вспышки в детских коллективах.
Пузырчатка новорожденных может вызываться и стафилококками. При наиболее тяжелой форме этого заболевания под роговым слоем кожи на значительных участках скапливается серозная жидкость и происходит отслоение кожного покрова в таких размерах, что ребенок производит впечатление «ошпаренного».
При стафилодермиях часто поражаются волосяные фолликулы, например на голове, что приводит к мелкой гнойничковой сыпи, которая после лечения бесследно исчезает.
Стафилококки вызывают не только местные, ограниченные поражения кожи, но и ангину, тяжелые пневмонии, воспалительные очаги в различных органах и тканях (в печени, селезенке, почках), возникающие в результате распространения микробов по кровеносным и лимфатическим путям. Смертельную угрозу несет с собой генерализованная стафилокковая инфекция — сепсис.
Стафилококки могут вызывать настоящие эпидемические вспышки в родильных домах и детских больницах. За счет их возникает подавляющая часть кожных и септических поражений новорожденных и гнойных заболеваний у матерей. Послеродовой сепсис, маститы, пневмонии, менингиты, воспаление родовых путей, конъюнктивиты являются настоящим бедствием. Конечно, они особенно опасны для рожениц и новорожденных детей.
Как происходит заражение
Передача возбудителей гнойно-септических инфекций происходит с воздухом (аэрогенно), например, при встряхивании постельного белья. Параллельно этому осуществляется передача через предметы быта, а также через пищу и воду. В последних случаях возникают пищевые токсикоинфекции.
В отношении же внутрибольничных случаев заражения наиболее опасны так называемые «госпитальные» штаммы золотистого стафилококка, устойчивые к внешним воздействиям и антибиотикам.
Стафилококки, будучи постоянными обитателями тела и жилья человека, естественно, концентрируются там, где повышена плотность размещения людей, где меньше вентиляция воздуха и больше возможностей для размножения и распространения микробов.
Именно такие условия нередко создаются в больничных палатах, где стафилококк распространяется с бельем, при встряхивании постелей, с пылью, при разговоре и кашле людей, находящихся в близком соседстве. Поэтому такие простые меры, как проветривание помещений, влажная уборка с дезинфицирующими средствами, пользование чистым бельем, своевременная смена постельных принадлежностей, облучение воздуха ультрафиолетом или просто доступ солнечного света значительно снижают концентрацию микробов и возможности их рассеивания.
Необходима тщательная санация — обследование и лечение людей с признаками стафилококковых и других подобных заболеваний. Кроме описанных выше гнойных поражений, у детей могут встречаться специфические инфекционные кожные заболевания, в том числе грибковой природы.
Кожный стафилококк — симптомы, лечение, исследование. Что такое Staphylococcus epidermidis?

Кожный стафилококк (Staphylococcus epidermidis) является потенциально смертельной бактерией, которая обычно встречается на коже, слизистой оболочке полости рта и в мочеполовых путях. Кто подвергается риску заражения кожным стафилококком? Какие заболевания вызывает кожный стафилококк? Как лечить инфекцию Staphylococcus epidermidis?
Бактерии кишечной палочки и метициллинрезистентный золотистый стафилококк (бактерии MRSA) являются опасными и очень быстро распространяющимися бактериями. Инфекция Staphylococcus aureus может вызывать такие заболевания, как пневмония, миокардит, флебит и менингит. В свою очередь, бактерия Escherichia coli (кишечная палочка), причина для инфекций мочевыводящих путей, уретрита, цистита. Последствия инфекции E.coli в значительной степени зависят от штамма бактерий.

Бактерия Escherichia coli
Между тем оказывается, что Staphylococcus epidermidis, то есть кожный стафилококк, является гораздо более опасной бактерией. Эта бактерия становится все более устойчивой к антибиотикам и вызывает опасные для жизни инфекции после операции.
Что такое кожный стафилококк?
Staphylococcus epidermidis, близкий родственник бактерий MRSA. Он настолько распространен, что содержится почти на коже почти у каждого человека. Кожный стафилококк является частью естественной бактериальной флоры, он не опасен, когда вы здоровы, — это смертельный микроорганизм, который встречается во всем мире и в большинстве случаев остается бездействующим.
Этот тип стафилококка часто игнорируется в клинических испытаниях, и из-за его повсеместного распространения он может очень быстро эволюционировать и генетически мутировать между бактериями.
Проблема с кожным стафилококком возникает, когда снижается иммунитет — тогда инфекция Staphylococcus epidermidis может вызвать ряд осложнений и стать фактором риска для многих заболеваний. Кожный стафилококк особенно опасен для людей, прошедших инвазивные процедуры.
Кожный стафилокок — симптомы
Симптомы активации стафилококковой инфекции :
Симптомы кожного стафилококка неспецифичны — каждый случай кожного стафилококка может иметь немного разные симптомы в зависимости от того, какая часть тела поражена. Люди, которым предстоит операция, должны обратить внимание на симптомы кожного стафилококка.
Кожный стафилококк у ребенка
Иммунная система ребенка более чувствительна, чем у взрослого, поэтому кожный стафилококк может быть опасным даже для самых маленьких. Если у ребенка есть повреждения кожи — его следует тщательно обработать, одеть и защитить от внешних факторов, чтобы избежать инфекции. Если у вашего ребенка изменения кожи без причины — обратитесь к врачу.
Стафилококки у ребенка могут вызвать фолликулит, стафилококковый сикоз, множественные абсцессы. Такие заболевания, как буллезное импетиго, буллезное воспаление и шелушение кожи, могут возникать в результате стафилококковой инфекции у новорожденных.
Кожный стафилококк — как можно заразиться?
Кожная стафилококковая инфекция возникает у пациентов с ослабленным иммунитетом,например, после тяжелой инфекции, после операции, после химиотерапии, у реципиентов органов и костного мозга. Бактерия попадает в кровоток и приводит к генерализованной инфекции, то есть к стафилококковой бактериемии.
Кожный стафилококк — какие заболевания может вызывать Staphylococcus epidermidis?
Проникнув в организм, стафилококк вызывает:
- перитонит;
- эндокардит;
- менингит;
- воспаления мочевыделительной системы;
- бактериемию;
- остеомиелит.
Кожный стафилококк — диагностика
Как выявить инфекцию Staphylococcus epidermidis? Для этого проводятся анализы крови, мочи и ткани из зараженной области кожи.

Диагностика стафилококка
Кожный стафилококк — лечение
Ученые из Центра эволюции Милнера при Университете Бата определили в стафилококковых бактериях кожи 61 ген, которые могут вызывать смертельные заболевания. Пробы были взяты у пациентов, перенесших инфекции после операции по замене тазобедренного или коленного сустава и фиксации перелома, и были сопоставлены с образцами мазков кожи от здоровых добровольцев.
Удивительно, что у некоторых здоровых людей, принявших участие в исследовании, были обнаружены еще более смертельные формы бактерий. Также было обнаружено, что Staphylococcus epidermidis образует биопленки, которые повышают сопротивляемость организма к антибиотикам.
Лечение кожного стафилококка предполагает использование антибиотиков. К сожалению, некоторые антибиотики не действуют против некоторых типов кожного стафилококка — лекарственная устойчивость кожного стафилококка аналогична таковой у золотистого стафилококка.
В случае штаммов с высокой лекарственной устойчивостью используются ванкомицин или тейкопланин, эффективные против стафилококков, включая штаммы, устойчивые к метициллину.
Золотистый стафилококк — возбудитель опаснейших заболеваний

Стафилококки — это бактериальные патогены, колонизирующие слизистые оболочки и кожу и вызывающие множество различных заболеваний у людей. Подсчитано, что до 30% всего населения могут быть носителями стафилококка.
Стафилококки чрезвычайно устойчивы к температуре и антибиотикам. В настоящее время известно 32 вида стафилококков, из которых 16 вызывают инфекции у человека. Наиболее распространены Staphylococcus epidermidis, Staphylococcus saprophyticus, Staphylococcus lugdunensis, Staphylococcus haemolyticus и Staphylococcus aureus.
Как обнаружить золотистый стафилококк — анализы
Диагноз стафилококковой инфекции ставится врачом на основании конкретных клинических симптомов и результатов микробиологических тестов, показывающих наличие стафилококков в биоматериале, полученном от пациента.
Основной лабораторный тест — это посев материала, взятого у пациента. Материалом может быть кровь, мокрота, гнойные выделения из раны, синовиальная жидкость, а в случае воспаления груди — материнское молоко. Иногда берут несколько проб из разных мест. Посев из носа также может обнаружить носительство стафилококка.
Образцы помещают на питательную среду и инкубируют в специальных условиях для оценки роста стафилококков. При положительном результате проводится тест на чувствительность выделенного стафилококка к антибиотикам, так называемая антибиотикограмма.
Выращивание материала обычно занимает около 24-48 часов. Есть также быстрые тесты, дающие результаты уже через несколько часов. Диагностика и лечение золотистого стафилококка сложные, поскольку носители могут иметь несколько видов стафилококка одновременно.
Врач диагностирует и проводит лечение золотистого стафилококка, в том числе на основании конкретных симптомов.
Чем опасна стафилококковая инфекция?
Инфекция, вызванная золотистым стафилококком, может быть локальной или системной. Некоторые заболевания вызываются стафилококковыми токсинами. Местные инфекции возникают в основном, когда золотистый стафилококк вызывает инфекции кожи и подкожной клетчатки, которые могут характеризоваться рядом патологий:
- наличием гнойных выделений, таких как фурункулы, фолликулит, абсцессы;
- воспаление потовых желез;
- мастит.
Реже наблюдается целлюлит или фасциит. Некротический фасциит может быть особенно опасным для жизни, требуя в большинстве случаев срочного хирургического вмешательства.
Золотистый стафилококк также вызывает бактериальный конъюнктивит, рецидивирующие респираторные инфекции, синусит и средний отит, а также может вызывать перитонзиллярные абсцессы, часто требующие хирургического вмешательства.
Чтобы подхватить стафилококк, достаточно слегка поранить кожу или съесть зараженную пищу. Помимо местных инфекций, золотистый стафилококк вызывает инвазивные инфекции, включая чрезвычайно опасный сепсис и эндокардит. Инфекции, чаще всего возникающие после травмы или хирургического вмешательства, могут поражать легкие, опорно-двигательную систему, почки или центральную нервную систему.
Золотистый стафилококк — один из ключевых этиологических факторов острого первичного остеоартроза.
Симптомы, вызванные энтеротоксинами золотистого стафилококка — стафилококковый токсический шок, который характеризуется:
- высокой температурой;
- диффузным поражением кожи;
- мышечными болями;
- рвотой и диареей;
- пищевым отравлением.
Если у пациента периодически возникают головные боли в области носовых пазух, частые инфекции миндалин и горла, плохо заживающие раны или другие тревожные изменения на коже, ему следует обследоваться на диагноз инфекции Staphylococcus aureus, чтобы в случае положительного результата соответствующее лечение было проведено как можно скорее.
Причины заражения и лечение
Причиной заражения может быть не только повреждение кожи или употребление зараженной пищи, но и контакт с инфицированным человеком — стафилококк может передаваться воздушно-капельным путем, через посуду, столовые приборы, полотенца.
Заражение может произойти в больницах, хирургических палатах, отделениях интенсивной терапии. Источником инфекции могут быть надувные трубки, катетеры и медицинское оборудование, использование которых потребовало нарушения целостности тканей.
Лечение золотистого стафилококка трудное и предполагает использование соответствующего антибиотика. Сроки излечимости стафилококка зависят от того, устойчив ли штамм к метициллину.
Эпидермальный стафилококк: болезни и лечение

Говоря о стафилококке, врачи чаще всего имеют в виду золотистый, ведь именно он является виновником более 90% инфекций, вызванных этой группой бактерий. Однако еще один вид этого условно-патогенного микроба, эпидермальный стафилококк, также способен спровоцировать заболевания. MedAboutMe разбирался, почему возникают такие болезни и как их следует лечить.
Симптомы эпидермального стафилококка
Этот микроб локализуется на коже, от чего и получил свое название «эпидермальный» («дерма» в переводе с латинского — кожа). Также он часто встречается на слизистых — в носу, горле, полости рта. В этих местах эпидермальный стафилококк обнаруживается практически у каждого человека и крайне редко вызывает какие-либо заболевания. Если инфекции все же удалось развиться, то проявляется она следующими симптомами:
- Гнойнички.
- Покраснение кожи.
- Шелушения.
- Язвочки.
Очень часто так проявляется стафилококк у детей — на щеках появляется покраснение и шелушащиеся участки кожи, которые часто принимаются за проявления аллергии.
Несмотря на то, что эпидермальный стафилококк часто находится на поверхности кожи и слизистых, он может попадать и внутрь организма. Именно здесь бактерия представляет наибольшую опасность. При заражении кишечника или других органов возникают такие симптомы:
- Общее ухудшение состояния — слабость, усталость, бледность.
- Повышение температуры.
- Расстройство стула, в кале обнаруживается слизь и даже гной.
- Тошнота, рвота.
Следует отметить, что признаки эпидермальной стафилококковой инфекции не являются специфическими, а сама она встречается крайне редко. Поэтому при таких заболеваниях необходимо обязательно сдавать анализы и точно определять возбудителя. В противном случае ложный диагноз может стать причиной осложнений.
Эпидермальный стафилококк у взрослых

Эпидермальный стафилококк относится к условно-патогенной микрофлоре и в подавляющем большинстве случаев не активизируется. Однако у людей с ослабленным иммунитетом он все же может вызывать описанные выше симптомы. Более того, у пациентов с иммунодефицитом микроб становится причиной развития обширного воспалительного процесса, который может привести к смерти. И все же в большинстве случаев эпидермальный стафилококк у взрослых причиняет неудобства при хирургических вмешательствах.
Дело в том, что он достаточно легко переносится по воздуху и может инфицировать открытые раны. Иногда попадает к больному в процессе операции. Особенно это касается протезирования — установки сердечных клапанов, суставов, шунтов и другого. Бактерия заносится на самом протезе и позже вызывает воспалительный процесс локального характера. Чаще всего такой стафилококк у взрослых вызывает повышение температуры и боли в конкретном месте. Больному назначается курс антибиотикотерапии, в тяжелых случаях протез удаляется.
Эпидермальный стафилококк — частая причина нагноений катетеров. В этом случае лечение сводится к замене инфицированного катетера другим. После устранения причины в большинстве случаев иммунная система сама справляется с очагом заражения, и курс антибиотиков не требуется, больному просто обрабатывается рана.
Еще одно проявление стафилококка у взрослых — инфицирование мочеиспускательного канала, которое чаще диагностируется у женщин. Болезнь переносится достаточно тяжело — повышается температура, заметно воспаление, появляются гнойные высыпания. Лечение в обязательном порядке включает антибиотики.
Эпидермальный стафилококк у детей
Поскольку детский организм обладает более слабым иммунитетом и только знакомится с различными бактериями, условно-патогенная микрофлора именно у ребенка чаще провоцирует заболевания. Эпидермальный стафилококк у детей может активизироваться уже в первые дни жизни. Проявляется он на коже — чаще на лице, складочках, в промежности. Основной причиной заражения в большинстве случаев становится несоблюдение правил гигиены — редкие купания и смена подгузников, грязная одежда.
Стафилококк у детей старшего возраста может проявляться на фоне череды заболеваний, которые ухудшают иммунитет. Например, во время адаптации к садику или школе, в поездках при смене климата, после пережитого стресса.
Основа лечения этого вида стафилококка, если он локализуется на коже и слизистых — местное воздействие на микробы и повышение иммунитета. Для ран и высыпаний может применяться зеленка, к которой достаточно чувствителен стафилококк.
Если же инфекция проникла в организм, потребуются медикаменты для перорального применения. Перед тем как назначать то или иное лекарство, врач должен получить анализы на чувствительность к антибиотикам.
Питание при эпидермальном стафилококке

Как уже говорилось, если эпидермальный стафилококк вызывает заболевание, это, в первую очередь, говорит о пониженном иммунитете. Поэтому лечение подобных инфекций базируется не только на медикаментах, но и на соблюдении правил здорового образа жизни. Прежде всего, речь идет о правильном питании. Очень важно не пропускать приемы пищи, а также отказаться от различных диет, особенно однокомпонентных.
Меню должно быть насыщенно витаминами, поэтому в рацион необходимо включать овощи и фрукты. Особенно такие:
- Зелень и овощи — сладкий перец, чеснок, укроп, листовой салат.
- Ягоды — черника, малина, вишня.
- Фрукты — абрикосы, яблоки, цитрусовые.
Салаты следует заправлять небольшим количеством растительного масла (кунжутное, оливковое), мясо и рыбу готовить на пару или запекать в духовке. Допустимы специи — кориандр, корица, имбирь. Консерванты, алкоголь, копчености и полуфабрикаты следует исключить.
Для тех, кто склонен к аллергиям, обязательно на время лечения стафилококковой инфекции нужно убрать из рациона все опасные продукты и не пропускать прием антигистаминных препаратов. Аллергические высыпания могут ухудшить состояние кожи и слизистых, а сама бактерия сможет через ранки проникнуть внутрь организма.
Для питья лучше всего использовать чистую воду (приблизительно 1,5—2 л в день). Особенно это важно, если стафилококк обнаружен в кишечнике — за счет обильного питья вы сможете понижать интоксикацию организма.
Читайте также:
- Признаки врожденных иммунодефицитов. Дефицит клеточного иммунитета у новорожденного
- Сифилис глазницы. Диагностика и рентгенография при сифилисе глаза
- Психическое состояние при героиновой наркомании. Отстутствие желания лечиться при наркомании
- Рентгенограмма, КТ, МРТ при синдроме Гризеля
- Диагностика инфекции. Клиническая диагностика инфекционной болезни
